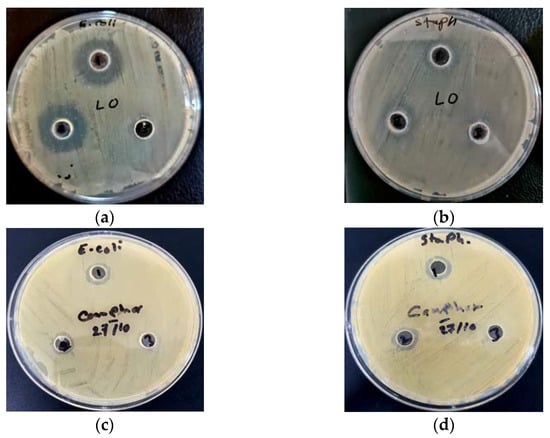

Abstract
The lavender Lavandula multifida L., a medicinal plant grown in arid regions of Tunisia, was recently considered an endangered species; thus, its habitats regressed to some difficult zones in terms of access, such as the watershed of Oued Agareb in central-eastern Tunisia. This species was recorded only in deep and narrow shady Wadi of the watershed and benefited from protection against overgrazing, erosion and sunlight. L. multifida was rarely observed in an open area, such as a plateau or large-bed valley. The plant’s metabolism is linked to its response to environmental conditions, which is of particular interest to understanding the components of the considered population of L. multifida. Consequently, biochemical and antimicrobial analyses have been evaluated. Using gas chromatography-mass spectrometry (GC-MS) analysis reveals that among the 58 compounds identified in L. multifida essential oil extracted from aboveground plant tissues, camphor was the major component (15.68%), followed by 1,8-cineole (14.14%) and alpha-pinene (13.82%). Moreover, it has been observed that Escherichia coli was more susceptible than Staphylococcus aureus to the antimicrobial properties of L. multifida essential oil, while in the case of camphor, S. aureus was more susceptible than E. coli. The protected population of L. multifida exhibits a distinctive vegetative development and growth cycle, resulting in specific secondary metabolites and distinguished antimicrobial activity.
1. Introduction
The family of Lamiaceae has been recognized for a long time as a source of many medicinal and aromatic species. The essential oil extracted from Lamiaceae species is proved by many studies to be of a high quality, and it was used by multiple industries, such as pharmaceutic and cosmetic, but especially in traditional medicine in many rural communities [1,2,3]. The commerce of plants and essential oils has increased considerably in both developed and developing countries [4]. In Lamiaceae species, the majority of the utilized material is derived from wild populations that have frequently been developed in disturbed environments [5,6,7]. Classical selection of medicinal plants (traditional selection) and biotechnological approaches for plant improvement (using biotechnological methods, such as tissue and organ culture, genetic transformation) were restricted to some renowned taxa (e.g., Mentha spp., Lavandula spp., Salvia spp., Ocimum spp., Origanum spp.). However, a severe decline and enormous loss, linked to both natural populations and many species belonging to the Lamiaceae family, have been reported during the last decade.
The harsh climate, the prolonged drought and the extension of agricultural fields by clearance, all aggravated by anthropogenic activities, such as overgrazing and urbanisation, are effective causes of the decline of wild Lamiaceae populations [8]. The harsh environmental conditions (climatic and edaphic factors), particularly in semi-arid and dry Mediterranean areas, have considerably contributed to increased genetic erosion. In North Africa, many species (such as Thymus capitatus, Lavandula multifida L., Lavandula stoechas, Ajuga iva and Mentha spp.) are endangered and grown in protected areas. Other species can only be found in old checklists [9,10].
The genus of Lavandula consists of about 51 wild and cultivated species grown in Mediterranean habitats [11]. Among them, L. angustifolia Mill. (Lavender), L. latifolia Medik., L. stoechas L., L. dentata L., L. pinnata Lundmark, L. lanata Boiss., L. mairei Humbert and L. multifida L. are the most appreciated and used in folk medicine and the cosmetic and pharmaceutic industries [12,13,14,15,16]. In Tunisia, the genus Lavandula includes three natural and popular species—L. stoechas, L. dentata and L. multifida—growing in semi-arid areas [17]. Le Floc’h (2008) [18] completed this list with the addition of another species, namely, L. coronopifolia Poiret in Lam. In the arid region of Tunisia, Lavandula has become rare and grows in very restricted protected zones, while sympatric populations are absent, as reported by Pottier-Alapetite [17]. In mid-eastern Tunisia, L. multifida is naturalised in habitats of semi-arid regions [19]. Furthermore, it has been adapted to some arid zones in southeastern regions of the country [17]. However, due to uncontrolled human harvesting of this species, as well as the overgrazing and regression of natural rangelands in the last decade, L. multifida has become an uncommon and endangered species [20].
L. multifida grows in open calcareous garrigues. The edaphic substratum is formed by the degradation of Pinus halepensis Mikll. and Juniperus phoenicea L. primary forests at an elevation ranging from 150 to 550 m [19]. Climatic traits of the native habitats are characterised by an annual rainfall between 350 and 450 mm, while the average annual temperature varies around 18 °C. The surrounding flora communities associated with L. multifida are usually composed of Thymelaea hirsuta L., Rosmarinus officinalis L., Oryzopsis miliacea L., Rhus tripartita D.C., Hyparrhenia hirta L., Thymus capitatus L., Thymus algeriensis L. and Ebenus pinnata Ait. In traditional medicine, L. multifida is used to treat many diseases, such as rheumatism [21], because of its inflammatory properties [22], as well as hypoglycemia [23]. In leaf extracts, a combination of luteolin 7-O-glycosides, hypolaetin-8-O-glycosides and isoscutellarin-8-O-glycosides and terpenoids (i.e., 15,16-dihydroxy-7,11-dioxopimar-8(9)-ene; 15S,16-dihydroxy-7-oxopimar-8(9)-ene) were investigated [24]. Ethanolic and aqueous extracts of the shoot system and aerial parts show high antioxidant activity [25]. Biochemical compounds were also identified in some populations of L. multifida grown in Tunisia [26]. Therefore, approximately 36 components, constituting 83.48% of the total oil, were identified in the essential oils extracted from the leaves of L. multifida. Carvacrol (31.81%), bisabolene (14.89%) and acrylic acid dodecyl ester (11.43%) were the major volatile components. These elements have also been identified as the main compounds of L. multifida selected from other Mediterranean habitats, including Morocco and Spain [27,28], where the main constituents were oxygenated monoterpenes (33.70%). Sesquiterpene hydrocarbons and b-bisabolene, with a percentage of 16.18% and 14.89%, respectively, of the oil are the most abundant components in this genus [26].
The habitat disturbance of L. multifida caused by overgrazing, uprooting of plants and cleaning activities has led to a regression of the species frequency. Such factors are linked to a disturbance, induced population fragmentation and large decrease in the size and number of individual plants, followed by a decrease of the green soil surface. The habitat’s degradation reduces the adaptive potential of L. multifida to environmental changes, causing it to possess more vulnerable populations [29].
The genetic variation within a population determines its ability to be maintained alive for long-term usage. As a result, analyzing genetic diversity within and across endangered species’ populations is critical to determine their future survival and to create improvement and conservation initiatives [30,31]. In Tunisia, because of Lavandula’s importance in traditional medicine and the pharmaceutic and cosmetic bio-industry, similar to most of the Lamiaceae species, L. multifida was over-exploited, leading to its becoming endangered [32,33]. Due to ongoing anthropogenic stresses, most L. multifida populations were fragmented and represented by scattered individuals in some protected locations [5]. Habitat fragmentation enhances population divergence and contributes to genetic diversity loss [30], while the maintenance of genetic variety is critical for population evolution and adaptability to environmental change [34]. As a result, understanding the current status of these endangered species (distribution area, regeneration capability, floral biology, genetic diversity) is critical to ensure their sensible usage.
The investigation of morphological heterogeneity, ecological adversity and population structure offers critical information for developing restorative initiatives and long-term conservation and improvement of the species [35,36]. The synthesis and accumulation of primary and secondary metabolites varies intensely amongst specimens of the same plant species cultivated under various environmental conditions and habitats [37,38,39]. Secondary metabolites that are stimulated by environmental factors (for example, water and salt stress in arid and semi-arid regions) act as a chemical interaction between the plant and its surroundings [38]. Plants and their environments interact largely through secondary metabolite production, which performs biological tasks, such as a flexible adaptive response to their habitats [40,41]. Therefore, the investigation of such discrepancies is extremely valuable for the chemical characterisation of individual plants of the same species collected from different habitats, especially in considering the different geographical origins of plant material [42,43]. These processes (genetic differences within a plant species) include either long-term acclimation or local adaptation, as well as seasonal variations in phenology, environmental fluctuations linked to biotic and abiotic factors and geographical disparities affecting diverse populations [44].
The aim of this research was the study of the morphological traits and ecological response of Lavandula multifida L. grown in the watershed of Agareb, one of the restricted areas of this species in mid-eastern Tunisia. Furthermore, secondary metabolites were analysed using GC-MS. Moreover, antibacterial properties were evaluated against two resistant strain bacteria, i.e., Escherichia coli and Staphylococcus aureus.
2. Materials and Methods
2.1. The Study Site
This study was carried out along 8 zones covering 29 stations in the Agareb region, which is considered a representative portion of the washout of Agareb (Figure 1). The Agareb region belongs to the Sahel of Sfax, located between latitudes 34°40′–34°50′ and longitudes 10°25′–10°45′. It is bounded from west to east by the plateaux of Jouaouda, Araba, El Gouna and Traka and the plains of Sfax, Ouled Ameur and Soualah.

Figure 1.
Study area, the watershed of Agareb in Sfax, Tunisia.
The watershed of Oued Agareb, located on the southern coast of Sfax and subjected to an irregular climate, is characterized by shallow topography, a soft structure and a dense river network. These factors make the watershed fragile, thus triggering various forms of soil degradation. Washouts and deep wadi are the fundamental erosion structures that characterise this region. As narrow and deep structures, washouts can hold many sensitive species, such as L. multifida, that cannot resist the climatic severity outside the river area.
The climate of the study zone is characterised by an annual mean temperature ranging from 2 to 24 °C, with mean annual precipitation of 196 mm. During the study period, the mean air temperature of the cold season was 12.1 ± 0.5 °C and that of the hot season 26.4 ± 1.4 °C; the rainfall varied from 7 mm during the dry period to 75 mm in autumn and 65 mm in winter. The climate traits are characteristic of a Mediterranean Lower Arid climate with temperate winter. The soil is an alkaline sandy loam, with gypsum outcrops and crumbly caliches at a depth of 10–25 cm. The topography is characterised by hills traversed by many valleys and gully erosion. The flora is composed of a remaining degraded steppe of Alfa grass Stipa tenacissima L., hosting a sparse perennial vegetation mainly composed of Artemisia herba-albaL., Artemisia campestris L., Thymelaea hirsuta Endl. and Retama raetam (Forssk.) Webb.
Washouts of Agareb have special geomorphology characterized by a network of many valleys. The studied zone is located in the Sahel Sfax, the eastern Tunisian platform. The Agareb region has a monotonous topography showing mounds with a curvature of a large radius, separated by wide valleys, plateaus and plains, generally subsiding and occupied by sebkhas (i.e., smooth flat plains sometimes occupied after a rain by a shallow lake). The altitudes rarely exceed 200 m. In this area, the highest altitudes reach 141 m at Hamadet El Houch and 183 m at Ksar El Merdjine. The eight study areas are represented by wadis and their edges, as well as the plateaus located in proximity. The depth and width of the wadi beds are the fundamental differences between the different sites.
2.2. Plant Material and Morphological Traits
Lavandula multifida L. that belongs to the Lamiaceae family—known by the vernacular name fern leaf lavender and Halhal, as well as wild Khezama, a local name—is an herbaceous perennial, highly aromatic, ever-blooming plant native to Southern Italy, Spain and Northern Africa (Morocco, Algeria, Tunisia and Libya) and frequently connected with open, disturbed regions and settlement.
The specimens were collected from eight sites along the studied washouts during the period 2019–2020. Dr. Khalil Mseddi (Botanic section) from the department of Biology, Faculty of Science, University of Sfax, has identified the plant at the species level. A voucher specimen (AGT 001) was deposited in the herbarium of the Department of Biology, University of Sfax, Tunisia.
The geographic coordinates were estimated by GPS. Ten morphological characteristics, i.e., root length (cm), number of root ramifications, root diameter (cm), stem length (cm), number of stem ramifications, leaf number per stem, spike length (cm), number of flowers per spike and flower length (cm), were measured in the collected samples.
2.3. Extraction of Essential Oil
Essential oils, also called volatile odoriferous oils, are aromatic oily liquids extracted from different parts of plants, such as the leaves, peels, barks, flowers, buds and seeds. They can be extracted from plant materials by several methods, including steam distillation, a method that has been widely used, especially for commercial-scale production. The composition of each essential oil depends not only on the family, but also on the part of the plant from which it is extracted, and sometimes on the soil where the plant grows, or even on the time of the harvest. Therefore, gas chromatography is necessary to characterize an essential oil.
Extraction of essential oil from the collected plant material was performed, as previously described by Baj et al. [45]. Briefly, 50 g of dried aerial parts of L. multifida collected from deep wadi in semi-arid Tunisia was placed into a round flask, and 400 mL of distilled water was added. The Hydro distillation was performed by a Clevenger apparatus (Glassco) for 3 h, according to the above-mentioned method. Extracted essential oils were collected in vials and stored at 4 °C until GC-MS analysis.
2.4. Chemical Analysis
The analysis was carried out using a gas chromatograph-mass spectrometer, GC-MS QP 2018, Shimadzu, equipped with a split-splitless injector and a ZB-5MS capillary column (30 m × 0.25 mm; 0.25 µm film).
2.5. Chromatographic Conditions
The column’s initial temperature was 45 °C, which was held for 2 min before ramping up to 280 °C at a rate of 5 °C per minute and then remaining steady for 5 min. The injector’s temperature was 265 °C. Helium (the carrier gas) flowed at a rate of 1 mL/min. The following conditions were applied for acquiring mass spectra: (instrument current) ionization voltage, 70 eV; ion source, 200 °C; filament emission current, 60 mA. Automatic essential oil injections were performed at a 1:15 split ratio, and the injection of the essential oil was at (1 µL,). The range of the mass spectrometric detector, which was in scan mode, was 35 to 550 m/z. By comparing mass spectra and retention indices in a high-quality Shimadzu mass spectral library, essential oils were identified.
2.6. Tested Microorganisms
Lavandula multifida L. is a member of the genus of Lavender that belongs to the mint family (Lamiaceae). These aromatic plants produce valuable and essential oils (EOs) in the manufacture of medicines, perfumes, cosmetics and food, as it has antioxidant properties and biological properties against the growth of many microorganisms, especially Candida albicans, Staphylococcus aureus and Escherichia coli. It is also widely used in folk medicine as an antispasm.
More than 95% of urinary tract infections are caused by E. coli, which is the most pathogenic organism. However, many other bacteria can also cause pathogenicity, such as Staphylococcus, Pseudomonas, Proteus, Klebsiella and Neisseria. Antibiotic resistance among E. coli has been recorded internationally, and growing resistance rates among E. coli are of increasing concern in both developed and developing countries.
The various components of plant extracts play an important role as antibacterial agents, as it has been suggested that vegetable oils act through the lipophilic part that interacts with the fatty parts of cell membranes. In recent years, multi-antibiotic resistance has arisen due to the indiscriminate use of antibiotics; hence, this problem requires efforts to find effective treatments by searching for effective materials against the microorganisms that cause these diseases. In addition, synthetic antibiotics are powerful and life-saving medicines. Yet, they do more harm than good when not used correctly; thus, there is also a need to develop alternative antimicrobial medicines to treat infectious diseases from other sources. The antibacterial properties of the essential oils of Lavandula multifida were evaluated against these two resistant bacteria strains, i.e., Escherichia coli and Staphylococcus aureus.
2.7. Antimicrobial Activity
The antimicrobial activity of the L. multifida essential oil was tested against two strains of pathogenic bacteria: Escherichia coli ATCC 8739 and Staphylococcus aureus ATCC 6583. The two microorganisms were derived from the culture collection of the QC department of the State company for the drugs industry and medical Appliance/Samarra-Iraq. The agar well diffusion method was employed for the determination of the antimicrobial activities of the tested diluted essential oil, as described by Oumzil et al. [46] with some modifications. Briefly, the test was performed in sterile Petri dishes containing Muller Hinton agar. A total of 6 wells (6 mm in diameter) were impregnated with 100 μL of oil and were placed on the Petri plates previously inoculated with a microbial suspension. The suspension of bacteria was obtained from 18 h cultures (one microorganism per Petri plate). All Petri plates were incubated at 37 °C for 24 h. The diameters of inhibition zones were measured in millimeters.
For determining the minimum inhibitory concentration (MIC) values of the essential oil and camphor material against the two bacterial strains, we tested 5 serial concentrations, ranging from 5 to 2.5, 1.25, 0.625 and 0.312 μg/mL. This method was done according to the CLSI protocol (CLSI, 2017), with some modifications as previously described by Sakkas et al. [47]. The dilutions of oil were prepared in Mueller–Hinton broth (MHB, Oxoid Ltd., Basingstoke, UK). Tween 20 (Thermo Fisher Scientific, Waltham, MA, USA) was used as a solubilizer at a concentration of 0.5% (v/v). Bacterial inoculum measured at turbidity of 0.5 McFarland (1–1.5 × 108 CFU/mL) was transferred into MHB to obtain a bacterial count of 5 × 105 CFU/mL. After incubation for 24 h at 37 °C, an appropriate amount of 10 µL was added to MHB and incubated for 24 h at 37 °C. The visible method was used for the determination of MIC value. The MIC is defined as the lowest concentration of an antimicrobial agent (EO) that prevents the visible growth of a microorganism in a broth dilution susceptibility test.
3. Results
3.1. Ecological Context and Distribution
Due to rangeland overgrazing and climate severity, L. multifida has become a rare species in the watershed of Oued Agareb. This work shows that the studied population exhibited shade preference strictly related to deep and narrow Wadi, which were the result of channel erosion along gully beds, whereas this species was absent in the open area of the plateau and hill zones (Table 1). This might be attributed to overgrazing and strong winter winds.

Table 1.
Coordinates and geomorphological traits of L. multifida habitats. Presence of L. multifida: −: absent; +: low density; ++: high density; +++: very high density.
However, it was seen as a random individual species only in the protected park of Algonna (created near the study zone), associated with some phanerophytes species, such as Retama reatam that can create a protective micro-environment and habitat and minimize sunlight effect. Hydraulic networks crossed by washouts were the fundamental erosion structures that can be seen in this region, which can support the growth of many sensitive species, such as Lavandula multifida, that cannot resist or tolerate the climatic severity outside the valley.
3.2. Communities Associated with L. multifida
The growth of L. multifida can be associated with that of numerous neighbor species (Table 2). However, it was observed that the species Retama raetam, Lycium shawii, Thymelaea hirsuta, Cenchrus ciliaris, Rhus tripartita and Aspargus albus were the nearest. These species can offer protection against both overgrazing and climate severity via their upright stem development and/or spiny leaves and stems.

Table 2.
Plant communities associated with Lavandula multifida in different study zones. Presence of L. multifida: −: absent; +: low density; ++: high density; +++: very high density.
Some other species can be associated in a distance of one to two meters around L. multifida. These species do not have any direct contact among aerial shoots, but they may communicate with their underground parts (rhizomes and roots). The most common species were Trigonella stellata, Stipa capensis, Rhanterium suaveolens, Lygeum spartum, Artemesia herba-alba, Gymnocarpos decander, Asparagus albus and Hyparrhenia hirta. Species such as Hammada scoparia, Artemisia campestris, Anabasis oropediorum, Ajuga iva, Peganum harmala, Periploca laevigata, Teucrium polium, Allium roseum, Fagonia cretica, Asparagus stipularis and Atractylis serratuloides were also seen in the same habitats as L. multifida.
3.3. Phenology and Life Cycle
According to the Raunkiaer classification [48], Lavandula multifida is a Chamaephyte (dwarf shrub) plant, exhibiting stems growing near the ground, and it bears dormant, hibernating buds that grow close to the ground, approximately 25 cm above the soil surface. The advantage of being close to the soil surface is that the buds can be protected from many negative environmental impacts. As a result, the chamaephyte habitat is more widespread in stressed niches, with prolonged periods of drought and severe herbivore grazing pressures.
Current varieties of L. multifida have an autumnal–winter life cycle, which is different than the European variety (spring–summer cycle) [49]. Indeed, this species grows rapidly and with high density just after the first autumnal rain (September–October), reaching maximum development in winter (Figure 2). L. multifida blossoms between late autumn and winter (i.e., from September to January). The development of fruits and seed dispersal are both completed in the beginning of spring. During the dry summer with elevated temperatures, the plants of L. multifida lose the majority of their leaves and become dry, woody shrubs bearing hidden buds during the unfavorable season.

Figure 2.
Life cycle of the Europe and the current variety of L. multifida.
3.4. Morphological Traits
The mean values of the considered parameters were calculated on collected samples from the study zones, and the results are presented in Table 3. The population of L. multifida in the Agareb region typically grows up to 58.7 cm height on straight stems with deeply lobed, lacy, silver-green leaves (Figure 3). It has been published that L. multifida is a perennial species (Missouri Botanical Garden, L. multifida); however, it is actually a sub-shrub because it develops woody stems over time in areas where it is winter resistant. Its roots can reach 41 cm in length and cross with other roots of neighbor plants, such as Cenchrus ciliaris and Retama reatam.

Table 3.
Morphological traits of the studied population of Lavandula multifida grown in the Agraeb region, a semi-arid area in Tunisia.

Figure 3.
Views of vegetative and reproductive parts of Lavandula multifida. (a) The whole plant (woody structure of shoot and root systems), (b) External leafy and internal naked shoot, (c) Deeply lobed leaves; (d) Inflorescence and flowers.
3.5. Composition of Essential Oil
Gas chromatography-mass spectrometry (GC-MS) analysis of the essential oil obtained from the leaves of L. multifida showed that among the 58 identified compounds, camphor was the major component (15.68%), followed by 1,8-cineole (14.14%) and alpha-pinene (13.82%) (Table 4). These major compounds are followed by Linalool L (9%), Linalyl anthranilate (6.08%), Borneol L (6.04%) and Delta 3-Carene (5.43%).

Table 4.
The composition (% w/w) of the essential oil of Lavandula multifida.
3.6. Minimum Inhibitory Concentration (MIC)
The results of the minimum inhibitory concentration of the L. multifida oil and synthetic camphor are shown in Table 5. A difference in the minimum inhibitory concentration between the extracted lavender oil and camphor was detected, but there was a similarity in their inhibitory concentrations on each one of the two bacteria.

Table 5.
Minimum Inhibitory Concentration (MIC) of L. multifida oil and camphor on E. coli and S. aureus.
3.7. Microbiological Activity
Measurement of the antibacterial activity of L. multifida essential oil against E. coli and S. aureus was made in comparison with the antibacterial activity of camphor as a major compound, in terms of concentration in GC analysis. According to the results (Table 6; Figure 4), a L. multifida oil concentration of 1.25 μg/mL possessed the highest inhibitory diameter (22.6 mm) on E. coli, compared to the lowest inhibitory diameter in S. aureus (17.8 mm), while the concentration of 0.625 μg/mL possessed the highest inhibitory diameter (21.3 mm) on E. coli, in comparison to the lower inhibition diameter on S. aureus (15.6 mm). In the case of camphor, the highest inhibition diameter (14.1 mm) was recorded on S. aureus at a concentration of 2.5 μg/mL of extract, in comparison to the lowest inhibition diameter recorded on E. coli (13.2 mm).

Table 6.
Biological activity of Lavandula multifida oil and Camphor against two bacteria.
Figure 4.
The biological activities of volatile (a,b) oil and camphor (c,d) from aerial organs of L. multifida against E. coli and S. aureus strains.
4. Discussion
Various studies have reported the genetic diversity [19,20,50] and the biochemical compositions [26,51] of different populations of Lavandula multifida. However, no previous works linking the morphological and phenological traits to the secondary metabolism and the essential oil composition have been reported. The current study shows that the morphological traits and habitat proprieties strongly affect the chemical composition of L. multifida essential oil and its antimicrobial activities.
In the current study, we found that the roots of L. multifida are 40 cm in length and 1 cm in diameter, a structure that may serve as either a drought tolerance or avoidance mechanism. The parameters of the shoots were quite different than those reported by Upson and Jury (2002) [52] for varieties of this species grown in Morocco. In addition, genetic analysis reported the high diversity in L. multifida populations from Tunisia [19,50].
The studied population starts its life cycle at the beginning of autumn with the first rain and rises to a maximum development in the end of the autumn and mid-winter. The blooming period is extended during winter, and fruiting is completed during spring. This life cycle is characteristic of the south Mediterranean population, i.e., North Africa regions [52]. However, in North Mediterranean regions (Spain and Italy), the flowering period begins in spring and is completed in summer [53].
Due to anthropogenic effects on the natural environment, L. multifida populations appear to be diminished and dispersed in North Africa (Morocco, Algeria, Tunisia, Egypt), Southern Spain and Portugal, Sicily, and Southern Italy [54,55,56]. Numerous of the above-mentioned studies have reported that biometric variables, such as morphological and reproductive parameters, display very different values, testifying to the high interspecific diversity [52]. Further, the secondary metabolism was related to environmental conditions [57].
In this study, 58 compounds were identified, and the major components were camphor (15.68%), 1,8-cineole (14.15%) and alpha-pinene (13.82%). Comparison with the previous study reported by Messaoud et al. [58] shows a different composition for the variety collected from the National Park of Bouhedma (Sidi Bouzid, Tunisia). The main components of L. multifida oil are carvacrol (65.1%) and beta-bisabolene (24.7%). In other work reported by Msaada et al. [51] on the variety collected from the Grombalia greenhouse (North-Eastern Tunisia), L. multifida oil was characterized by the predominance of linalool (50.05%), camphene (10.06%), linalyl acetate (7.30%), α-thujene (3.83%), bornyl acetate (3.03%), β-caryophellene (2.13%), nerol (2.01%) and terpinolene (2.05%). Chograni et al. [26] reported a different essential oil composition when they studied twelve populations of L. multifida collected from different bioclimatic areas in Tunisia. The major components at the species level were carvacrol (31.81%), beta-bisabolene (14.89%) and acrylic acid dodecyl ester (11.43%).
In North Africa countries, Saadi et al. (2016) [59] have reported that the major components of L. multifida essential oil growing in Algeria was carvacrol (61.73%) in inflorescence and (50.92%) in leaves, followed by linalool (5.69%) in inflorescence and anethole (17.37%) in leaves. Znini et al. (2019) [60] identified carvacroal (65.6%) as the major compound, followed by spathulenol (8.6%) and Para-Gymen-8-ol, in L. multifida grown in Morocco. These differences in essential oil composition are probably linked to micro-environmental conditions, such as soil, light, temperature and humidity.
The diversity of the composition of the volatile oil obtained from different accessions of L. multifida can be explicated by endogenous (plant varieties, vegetative state, organ tested) and exogenous factors, such as climatic features, soil characteristics and seasons [61].
The biological activity of L. multifida essential oil against gram-negative and gram-positive bacteria may be due to the effect of its chemical components, especially linalool and comphor. Our results are consistent with previous investigations, which evaluated the MIC of linalool for L. augustifolia (52.59%), exhibiting biological activity against gram-negative and gram-positive bacteria at a concentration of 1.25 μg/mL [62]. However, Jianu et al. (2013) [63] published the effect of L. augustifolia essential oil with a high content of camphor against S. aureus and E. coli. In another study [64], it was shown that L. hybrida essential oil containing linalool (32.8%) has inhibitory activity against S. aureus, while the opposite holds true for E. coli. Moreover, it has been published that the essential oil of Lavandula stoechas possesses inhibitory activity against both E. coli and S. aureus at MIC limits, which range between 0.16 and11.9 μg/mL [65].
Based on our findings, the essential oil of L. multifida was found to be more active against the used bacterial strains than camphor. As has been reported by Xu et al. (2005) [66], camphor’s mode of action on the development of microorganisms involves disruption of the phospholipid bilayer structure, interaction with membrane enzymes and proteins, and acting as a proton exchanger. The higher antibacterial activity of L. multifida essential oil against S. aureus and E. coli in comparison with camphor could be explained by the synergistic action of the components of this essential oil extract, especially the linalool and camphor content.
The extracted lavender oil from aerial plant tissues of L. multifida was biologically effective on gram-negative and gram-positive bacteria because it contained multiple biologically active substances, including camphor, which, in turn, exhibited an inhibitory effect against bacteria. The spread of L. multifida within the biodiversity of naturally growing plants in the valley seems to play a key role in the diversity of the extracted compounds.
Author Contributions
Conceptualization, M.L.T., K.M. and R.G.; methodology, K.M., L.K. and A.K.; formal analysis, M.L.T., A.B.Y., A.K. and O.K.A.-A.; investigation, O.K.A.-A. and A.B.Y.; data curation, L.K. and M.L.T.; writing—original draft preparation, K.M., M.L.T. and O.K.A.-A.; writing—review and editing, K.M. and R.G.; project administration, R.G. and K.M. All authors have read and agreed to the published version of the manuscript.
Funding
This research received no external funding.
Institutional Review Board Statement
Not applicable.
Informed Consent Statement
Not applicable.
Data Availability Statement
All data generated by this project are included in the paper.
Acknowledgments
The authors would like to thank “The State Company for Drugs Industry and Medical Appliances, Samarra, Iraq”.
Conflicts of Interest
The authors declare no conflict of interest.
References
- Mseddi, K.; Alimi, F.; Noumi, E.; Veettil, V.N.; Deshpande, S.; Adnan, M.; Hamdi, A.; Elkahoui, S.; Alghamdi, A.; Kadri, A.; et al. Thymus Musilii Velen. as a Promising Source of Potent Bioactive Compounds with Its Pharmacological Properties: In Vitro and in Silico Analysis. Arab. J. Chem. 2020, 13, 6782–6801. [Google Scholar] [CrossRef]
- Napoli, E.; Siracusa, L.; Ruberto, G. New Tricks for Old Guys: Recent Developments in the Chemistry, Biochemistry, Applications and Exploitation of Selected Species from the Lamiaceae Family. Chem. Biodivers. 2020, 17, e1900677. [Google Scholar] [CrossRef] [PubMed]
- Pourhosseini, S.H.; Mirjalili, M.H.; Ghasemi, M.; Ahadi, H.; Esmaeili, H.; Ghorbanpour, M. Diversity of Phytochemical Components and Biological Activities in Zataria Multiflora Boiss. (Lamiaceae) Populations. S. Afr. J. Bot. 2020, 135, 148–157. [Google Scholar] [CrossRef]
- Drioiche, A.; Benhlima, N.; Kchibale, A.; Boutahiri, S.; Ailli, A.; El Hilali, F.; Moukaid, B.; Zair, T. Ethnobotanical Investigation of Herbal Food Additives of Morocco Used as Natural Dyes. Ethnobot. Res. Appl. 2021, 21, 1–43. [Google Scholar] [CrossRef]
- Boussaïd, M.; Ben Fadhel, N.; Chemli, R.; Ben M’hamed, M. Structure of Vegetation in Northern and Central Tunisia and Protective Measures. Cah. Options Méditerranéennes 1999, 38, 295–302. [Google Scholar]
- Rasheed, A.; Rasool, S.G.; Soriano, P.; Estrelles, E.; Gul, B.; Hameed, A. Ecophysiological and Biochemical Responses Depicting Seed Tolerance to Osmotic Stresses in Annual and Perennial Species of Halopeplis in a Frame of Global Warming. Life 2022, 12, 2020. [Google Scholar] [CrossRef]
- Aili, A.; Xu, H.; Zhao, X.; Zhang, P.; Yang, R. Dynamics of Vegetation Productivity in Relation to Surface Meteorological Factors in the Altay Mountains in Northwest China. Forests 2022, 13, 1907. [Google Scholar] [CrossRef]
- García-Caparrós, P.; Romero, M.J.; Llanderal, A.; Cermeño, P.; Lao, M.T.; Segura, M.L. Effects of Drought Stress on Biomass, Essential Oil Content, Nutritional Parameters, and Costs of Production in Six Lamiaceae Species. Water 2019, 11, 573. [Google Scholar] [CrossRef]
- Mehalaine, S.; Chenchouni, H. New Insights for the Production of Medicinal Plant Materials: Ex Vitro and in Vitro Propagation of Valuable Lamiaceae Species from Northern Africa. Curr. Plant Biol. 2021, 27, 100216. [Google Scholar] [CrossRef]
- El-Banhawy, A.; Al-Juhani, W. DNA Barcoding and Phylogeny of Phlomis Aurea (Lamiaceae) Endemic to Sinai Peninsula, Egypt. Pak. J. Bot 2019, 51, 1263–1271. [Google Scholar] [CrossRef]
- Stefanaki, A.; van Andel, T. Mediterranean Aromatic Herbs and Their Culinary Use. In Aromatic Herbs in Food; Elsevier: Amsterdam, The Netherlands, 2021; pp. 93–121. [Google Scholar]
- Bousta, D.; Farah, A. A Phytopharmacological Review of a Mediterranean Plant: Lavandula Stoechas L. Clin. Phytoscience 2020, 6, 9. [Google Scholar]
- Aprotosoaie, A.C.; Gille, E.; Trifan, A.; Luca, V.S.; Miron, A. Essential Oils of Lavandula Genus: A Systematic Review of Their Chemistry. Phytochem. Rev. 2017, 16, 761–799. [Google Scholar] [CrossRef]
- Détár, E.; Németh, É.Z.; Gosztola, B.; Demján, I.; Pluhár, Z. Effects of Variety and Growth Year on the Essential Oil Properties of Lavender (Lavandula Angustifolia Mill.) and Lavandin (Lavandula x Intermedia Emeric Ex Loisel.). Biochem. Syst. Ecol. 2020, 90, 104020. [Google Scholar] [CrossRef]
- El Hamdaoui, A.; Msanda, F.; Boubaker, H.; Leach, D.; Bombarda, I.; Vanloot, P.; El Aouad, N.; Abbad, A.; Boudyach, E.H.; Achemchem, F. Essential Oil Composition, Antioxidant and Antibacterial Activities of Wild and Cultivated Lavandula Mairei Humbert. Biochem. Syst. Ecol. 2018, 76, 1–7. [Google Scholar] [CrossRef]
- Benbrahim, C.; Barka, M.S.; Basile, A.; Maresca, V.; Flamini, G.; Sorbo, S.; Carraturo, F.; Notariale, R.; Piscopo, M.; Khadir, A. Chemical Composition and Biological Activities of Oregano and Lavender Essential Oils. Appl. Sci. 2021, 11, 5688. [Google Scholar] [CrossRef]
- Alapetite, G.P. Flore de La Tunisie, Angiospermes-Dicotylédones, Gamopétales; Imprimerie Officielle de la République Tunisienne: Tunisia, Tunisie, 1981. [Google Scholar]
- Le Floc’h, É.; Boulos, L.; Véla, E. Catalogue Synonymique Commenté de La Flore de Tunisie; République Tunisienne. Ministère L’Environnement du Développement Durable, Banq. Natl. Gènes: Tunisia, Tunisie, 2010. [Google Scholar]
- Chograni, H.; Messaoud, C.; Boussaid, M. Genetic Diversity and Population Structure in Tunisian Lavandula Stoechas L. and Lavandula Multifida L. (Lamiaceae). Biochem. Syst. Ecol. 2008, 36, 349–359. [Google Scholar] [CrossRef]
- Chograni, H.; Boussaid, M. Genetic Structure of Tunisian Spontaneous Populations of Lavandula Multifida L. Les Ann. l’INRGREF 2009, 13, 139–152. [Google Scholar]
- El-Hilaly, J.; Hmammouchi, M.; Lyoussi, B. Ethnobotanical Studies and Economic Evaluation of Medicinal Plants in Taounate Province (Northern Morocco). J. Ethnopharmacol. 2003, 86, 149–158. [Google Scholar] [CrossRef]
- Mammeri, A.; Bendif, H.; Bensouici, C.; Benslama, A.; Rebas, K.; Bouasla, A.; Rebaia, I.; Souilah, N.; Miara, M.D. Total Phenolic Contents, in Vitro Antioxidant Activity, Enzymes Inhibition and Antiinflammatory Effect of the Selective Extracts from the Algerian Lavandula Multifida. ACTA Pharm. Sci. 2022, 60, 1–23. [Google Scholar] [CrossRef]
- Gamez, M.J.; Jimenez, J.; Risco, S.; Zarzuelo, A. Hypoglycemic Activity in Various Species of the Genus Lavandula. I: Lavandula Stoechas L. and Lavandula Multifida L. Pharmazie 1987, 42, 706–707. [Google Scholar]
- Politi, M.; De Tommasi, N.; Pescitelli, G.; Di Bari, L.; Morelli, I.; Braca, A. Structure and Absolute Configuration of New Diterpenes from Lavandula m Ultifida. J. Nat. Prod. 2002, 65, 1742–1745. [Google Scholar] [CrossRef]
- Neffati, N.; Aloui, Z.; Karoui, H.; Guizani, I.; Boussaid, M.; Zaouali, Y. Phytochemical Composition and Antioxidant Activity of Medicinal Plants Collected from the Tunisian Flora. Nat. Prod. Res. 2017, 31, 1583–1588. [Google Scholar] [CrossRef] [PubMed]
- Chograni, H.; Zaouali, Y.; Rajeb, C.; Boussaid, M. Essential Oil Variation among Natural Populations of Lavandula Multifida L. (Lamiaceae). Chem. Biodivers. 2010, 7, 933–942. [Google Scholar] [CrossRef] [PubMed]
- Bellakhdar, J.; Berrada, M.; Denier, C.; Holeman, M.; Ilidrissi, A. Comparative Chemical Study of the Essential Oils of Ten Populations of Lavandula Multifida L. from Morocco. Biruiya 1985, 1, 95–106. [Google Scholar]
- Ribeiro, S.O.; Fraselle, S.; Baudoux, D.; Zhiri, A.; Stévigny, C.; Souard, F. Proposals for Antimicrobial Testing Guidelines Applied on Ajowan and Spanish Lavender Essential Oils. Planta Med. 2021, 87, 754–763. [Google Scholar] [CrossRef] [PubMed]
- de Santana, N.S.; Santos, A.S.; Borges, D.B.; de Souza França, D.; Reis, J.B.L.; de Oliveira, F.A.; Barreto, M.A.; Corrêa, R.X.; Zucchi, M.I.; Martins, K. Genetic Resilience of Atlantic Forest Trees to Impacts of Biome Loss and Fragmentation. Eur. J. For. Res. 2022, 1–14. [Google Scholar] [CrossRef]
- Hamrick, J.L.; Godt, M.J.W. Allozyme Diversity in Plant Species; Plant Population Genetics, Breeding, and Genetic Resources; Sinauer Associates Inc.: Sunderland, MA, USA, 1990; pp. 43–63. [Google Scholar]
- Godt, M.J.W.; Caplow, F.; Hamrick, J.L. Allozyme Diversity in the Federally Threatened Golden Paintbrush, Castilleja Levisecta (Scrophulariaceae). Conserv. Genet. 2005, 6, 87–99. [Google Scholar] [CrossRef]
- Fadhel, N.B.; Boussaïd, M. Genetic Diversity in Wild Tunisian Populations of Mentha Pulegium L. (Lamiaceae). Genet. Resour. Crop Evol. 2004, 51, 309–321. [Google Scholar] [CrossRef]
- Zaouali, Y.; Messaoud, C.; Salah, A.B.; Boussaid, M. Oil Composition Variability among Populations in Relationship with Their Ecological Areas in Tunisian Rosmarinus Officinalis L. Flavour Fragr. J. 2005, 20, 512–520. [Google Scholar] [CrossRef]
- Teixeira, J.C.; Huber, C.D. The Inflated Significance of Neutral Genetic Diversity in Conservation Genetics. Proc. Natl. Acad. Sci. USA 2021, 118, e2015096118. [Google Scholar] [CrossRef]
- Avise, J.C. Toward a Regional Conservation Genetics Perspective: Phylogeography of Faunas in the Southeastern United States. In Conservation Genetics; Springer: Berlin/Heidelberg, Germany, 1996; pp. 431–470. ISBN 0412145812. [Google Scholar]
- Gitzendanner, M.A.; Soltis, P.S. Patterns of Genetic Variation in Rare and Widespread Plant Congeners. Am. J. Bot. 2000, 87, 783–792. [Google Scholar] [CrossRef]
- Yang, L.; Wen, K.-S.; Ruan, X.; Zhao, Y.-X.; Wei, F.; Wang, Q. Response of Plant Secondary Metabolites to Environmental Factors. Molecules 2018, 23, 762. [Google Scholar] [CrossRef] [PubMed]
- Sharma, A.; Shahzad, B.; Rehman, A.; Bhardwaj, R.; Landi, M.; Zheng, B. Response of Phenylpropanoid Pathway and the Role of Polyphenols in Plants under Abiotic Stress. Molecules 2019, 24, 2452. [Google Scholar] [CrossRef] [PubMed]
- Khalid, K.A. Evaluation of Leaf, Flower and Peel Bitter Orange Essential Oils and Their Constituents in Response to Various Planting Locations of Egypt. J. Essent. Oil Bear. Plants 2022, 25, 208–218. [Google Scholar] [CrossRef]
- Sampaio, B.L.; Edrada-Ebel, R.; Da Costa, F.B. Effect of the Environment on the Secondary Metabolic Profile of Tithonia Diversifolia: A Model for Environmental Metabolomics of Plants. Sci. Rep. 2016, 6, 29265. [Google Scholar] [CrossRef]
- Isah, T. Stress and Defense Responses in Plant Secondary Metabolites Production. Biol. Res. 2019, 52, 39. [Google Scholar] [CrossRef] [PubMed]
- Rani, A.; Kashyap, R.; Azmi, W. Conservation of Biodiversity by Biotechnology. In Basic Concepts in Environmental Biotechnology; CRC Press: Boca Raton, FL, USA, 2021; pp. 149–175. ISBN 1003131425. [Google Scholar]
- Sampaio, B.L.; Costa, F.B. Da Influence of Abiotic Environmental Factors on the Main Constituents of the Volatile Oils of Tithonia Diversifolia. Rev. Bras. Farmacogn. 2018, 28, 135–144. [Google Scholar] [CrossRef]
- Giordano, A.; Fuentes-Barros, G.; Castro-Saavedra, S.; González-Cooper, A.; Suárez-Rozas, C.; Salas-Norambuena, J.; Acevedo-Fuentes, W.; Leyton, F.; Tirapegui, C.; Echeverría, J. Variation of Secondary Metabolites in the Aerial Biomass of Cryptocarya Alba. Nat. Prod. Commun. 2019, 14, 1934578X19856258. [Google Scholar] [CrossRef]
- Baj, T.; Sieniawska, E.; Kowalski, R.; Wesolowski, M.; Ulewicz-Magulska, B. Effectiveness of the Deryng and Clevenger-Type Apparatus in Isolation of Various Types of Components of Essential Oil from the Mutelina Purpurea Thell. Flowers. Acta Pol. Pharm 2015, 72, 507–515. [Google Scholar]
- Oumzil, H.; Ghoulami, S.; Rhajaoui, M.; Ilidrissi, A.; Fkih-Tetouani, S.; Faid, M.; Benjouad, A. Antibacterial and Antifungal Activity of Essential Oils of Mentha Suaveolens. Phyther. Res. 2002, 16, 727–731. [Google Scholar] [CrossRef]
- Sakkas, H.; Gousia, P.; Economou, V.; Sakkas, V.; Petsios, S.; Papadopoulou, C. In Vitro Antimicrobial Activity of Five Essential Oils on Multidrug Resistant Gram-Negative Clinical Isolates. J. Intercult. Ethnopharmacol. 2016, 5, 212. [Google Scholar] [CrossRef] [PubMed]
- Raunkiaer, C. The Life Forms of Plants and Statistical Plant Geography Being the Collected Papers of C. Raunkiaer; Oxford at the Clarendon Press: Oxford, UK, 1934. [Google Scholar]
- Mifsud, S. Lavandula multifida (Fern-Leaved Lavender): MaltaWildPlants. Com-the Online Flora of the Maltese Islands. 2002. Available online: https://maltawildplants.com/LABT/Lavandula_multifida.php (accessed on 21 September 2022).
- Hnia, C.; Mohamed, B. Genetic Diversity of Lavandula multifida L. (Lamiaceae) in Tunisia: Implication for Conservation. Afr. J. Ecol. 2011, 49, 10–20. [Google Scholar] [CrossRef]
- Msaada, K.; Salem, N.; Tammar, S.; Hammami, M.; Jamal Saharkhiz, M.; Debiche, N.; Limam, F.; Marzouk, B. Essential Oil Composition of Lavandula Dentata, L. Stoechas and L. Multifida Cultivated in Tunisia. J. Essent. Oil Bear. Plants 2012, 15, 1030–1039. [Google Scholar] [CrossRef]
- Upson, T.M.; Jury, S.L. A Revision of Native Moroccan Species of Lavandula L. Section Pterostoechas Ging. (Lamiaceae). Taxon 2002, 51, 309–327. [Google Scholar] [CrossRef]
- Panuccio, M.R.; Fazio, A.; Musarella, C.M.; Mendoza-Fernández, A.J.; Mota, J.F.; Spampinato, G. Seed Germination and Antioxidant Pattern in Lavandula Multifida (Lamiaceae): A Comparison between Core and Peripheral Populations. Plant Biosyst. Int. J. Deal. with all Asp. Plant Biol. 2018, 152, 398–406. [Google Scholar] [CrossRef]
- The Euro+Med PlantBase. The Information Resource for Euro-Mediterranean Plant Diversity. 2011. Available online: https://www.emplantbase.org/home.html (accessed on 21 September 2022).
- Blanca, G.; Cabezudo, B.; Cueto, M.; Salazar, C.; Morales Torres, C. Flora Vascular de Andalucía Oriental; Junta de Andalucia. Consejeria de Medio Ambiente: Andalucia, Spain, 2009; Volume 4. [Google Scholar]
- Tutin, T.G.; Heywood, V.H.; Burges, N.A.; Valentine, D.H.; Walters, S.M.; Webb, D.A. Flora Europaea: Plantaginaceae to Compositae (and Rubiaceae); Cambridge University Press: Cambridge, UK, 1964; Volume 4, ISBN 0521087171. [Google Scholar]
- Ashraf, M.A.; Iqbal, M.; Rasheed, R.; Hussain, I.; Riaz, M.; Arif, M.S. Environmental Stress and Secondary Metabolites in Plants: An Overview. In Plant Metabolites and Regulation under Environmental Stress; Academic Press: Cambridge, MA, USA, 2018; pp. 153–167. [Google Scholar]
- Messaoud, C.; Chograni, H.; Boussaid, M. Chemical Composition and Antioxidant Activities of Essential Oils and Methanol Extracts of Three Wild Lavandula L. Species. Nat. Prod. Res. 2012, 26, 1976–1984. [Google Scholar] [CrossRef]
- Saadi, A.; Brada, M.; Kouidri, M.; Dekkiche, H.; Attar, F. Chemical Composition and Content of Essential Oil of Lavandula Multifida from Algeria. Chem. Nat. Compd. 2016, 52, 162–164. [Google Scholar] [CrossRef]
- Znini, M.; Laghchimia, A.; Paolinib, J.; Costab, J.; Majidia, L. Characterization of Lavandula Multifida Volatile Composition from Morocco by Headspace Solid-Phase Microextraction (HS-SPME) and Hydrodistillation Coupled to GC–MS. Arab. J. Med. Aromat. Plants 2019, 5, 18–31. [Google Scholar]
- Vaičiulytė, V.; Ložienė, K.; Taraškevičius, R. Impact of Edaphic and Climatic Factors on Thymus Pulegioides Essential Oil Composition and Potential Prevalence of Chemotypes. Plants 2022, 11, 2536. [Google Scholar] [CrossRef]
- Danh, L.T.; Han, L.N.; Triet, N.D.A.; Zhao, J.; Mammucari, R.; Foster, N. Comparison of Chemical Composition, Antioxidant and Antimicrobial Activity of Lavender (Lavandula Angustifolia L.) Essential Oils Extracted by Supercritical CO2, Hexane and Hydrodistillation. Food Bioprocess Technol. 2013, 6, 3481–3489. [Google Scholar] [CrossRef]
- Jianu, C.; Pop, G.; TGruia, A.; Horhat, F.G. Chemical Composition and Antimicrobial Activity of Essential Oils of Lavender (Lavandula Angustifolia) and Lavandin (Lavandula x Intermedia) Grown in Western Romania. Int. J. Agric. Biol. 2013, 15, 772–776. [Google Scholar]
- Andoğan, B.C.; Baydar, H.; Kaya, S.; Demirci, M.; Özbaşar, D.; Mumcu, E. Antimicrobial Activity and Chemical Composition of Some Essential Oils. Arch. Pharm. Res. 2002, 25, 860–864. [Google Scholar] [CrossRef] [PubMed]
- Benabdelkader, T.; Zitouni, A.; Guitton, Y.; Jullien, F.; Maitre, D.; Casabianca, H.; Legendre, L.; Kameli, A. Essential Oils from Wild Populations of Algerian Lavandula Stoechas L.: Composition, Chemical Variability, and in Vitro Biological Properties. Chem. Biodivers. 2011, 8, 937–953. [Google Scholar] [CrossRef] [PubMed]
- Xu, H.; Blair, N.T.; Clapham, D.E. Camphor Activates and Strongly Desensitizes the Transient Receptor Potential Vanilloid Subtype 1 Channel in a Vanilloid-Independent Mechanism. J. Neurosci. 2005, 25, 8924–8937. [Google Scholar] [CrossRef] [PubMed]
Disclaimer/Publisher’s Note: The statements, opinions and data contained in all publications are solely those of the individual author(s) and contributor(s) and not of MDPI and/or the editor(s). MDPI and/or the editor(s) disclaim responsibility for any injury to people or property resulting from any ideas, methods, instructions or products referred to in the content. |
© 2022 by the authors. Licensee MDPI, Basel, Switzerland. This article is an open access article distributed under the terms and conditions of the Creative Commons Attribution (CC BY) license (https://creativecommons.org/licenses/by/4.0/).